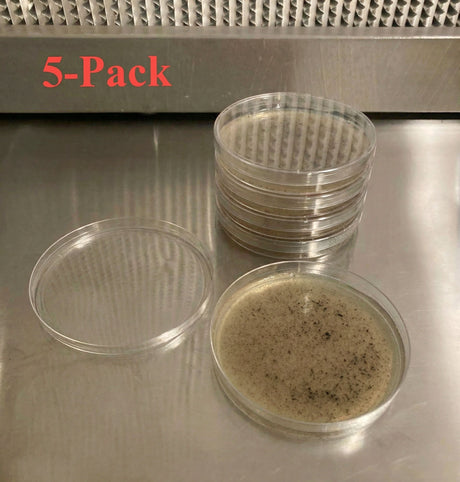

Microppose Reusable Autoclavable Petri Dishes – 90mm x 15mm (20-Pack Sleeve)
$1199$1999Unit price /UnavailablePre-Poured Willy’s Blend Manure Enriched Agar Plates - Conditioning Agar Plates (5-Pack)
$1299$1499Unit price /UnavailableMyco Labs Light Malt Extract (LME) Agar Powder Blend - Makes 200+ Agar Plates 200g (7oz)
$1999$2499Unit price /UnavailableMicroppose Petri Dishes 90mm x 15mm Plates | Vented Lid | Polystyrene Sterile |500-Pack
From $7999$8799Unit price /Unavailable- From $9999
$12999Unit price /Unavailable
How to Choose the Right Agar Supplies
Not every grower needs every tool. Here's how to match supplies to where you are in your cultivation journey.
If you're new to agar work
Start with pre-poured agar plates. They arrive sterile and ready to inoculate — no autoclave, no mixing, no contamination risk from your own pour. Pair them with a disposable scalpel and an alcohol lamp, and you have a complete starter setup. Most new growers use plates to test liquid culture syringes for clean growth before committing them to grain.
If you want to preserve genetics long-term
Move to agar slants. Plates last a few weeks in the fridge; slants last up to a year thanks to denser media and a sealed tube. Transfer your best-performing mycelium from a plate to a slant and you've banked that genetic for future grows without repeated transfers.
If you're pouring your own media
You'll want autoclavable Petri dishes (reusable, vented), along with your choice of media — MEA (malt extract agar) is the standard for most gourmet and exotic species. Add scalpels, alcohol lamps, and syringes to round out the lab.
If you're isolating or cloning
Sterile disposable scalpels are non-negotiable — every transfer is a contamination risk, and a fresh blade eliminates one variable. An alcohol lamp for flame-sterilizing your inoculation loop or needle is the other essential.
Frequently Asked Questions About Agar Supplies
Do I need agar to grow mushrooms?
No — you can grow mushrooms with just spores or liquid culture and grain spawn. But agar dramatically improves your success rate by letting you visually confirm clean mycelium before inoculating expensive grain. Most experienced growers consider agar essential once they move past their first few grows.
How long do pre-poured agar plates last?
Refrigerated and sealed, pre-poured plates stay viable for several weeks. Our plates ship within days of pouring, so you get the full shelf life. For long-term storage of genetics, transfer to agar slants, which last up to a year.
What's the difference between MEA and other agar types?
Malt Extract Agar (MEA) is the standard nutrient medium for most gourmet mushroom species. It supports strong, healthy mycelium growth and clearly shows contamination. Specialty media exist for specific applications, but MEA covers the vast majority of cultivation needs.
Can I test a liquid culture syringe on an agar plate?
Yes, and you should. Streaking a small amount of LC onto an agar plate lets you confirm clean, vigorous growth before committing the rest of the syringe to grain spawn. It's one of the highest-value uses of agar for hobbyist growers.
Do I need a still air box or flow hood for agar work?
A still air box (SAB) is the minimum for clean agar work and is inexpensive to build. A laminar flow hood is the gold standard and dramatically reduces contamination, but it's an investment most growers make after their first year.
What's the difference between agar plates and slants?
Plates are Petri dishes used for active work — inoculating, isolating, cloning. Slants are angled test tubes used for long-term storage. Use plates to work with cultures, slants to preserve them.